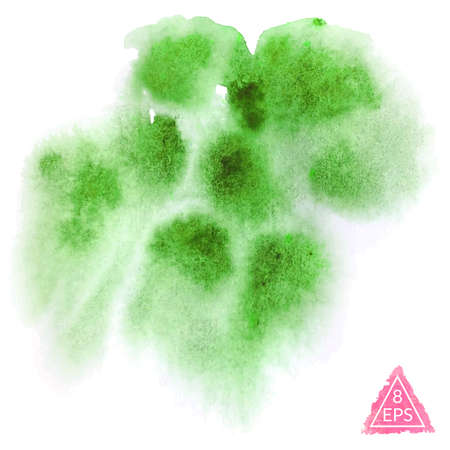
Vector watercolor blot. Hand drawn blot on white background for your design. Save the Date, postcard, banner, logo.のイラスト素材

イラスト素材 - Vector watercolor blot. Hand drawn blot on white background for your design. Save the Date, postcard, banner, logo.
作品情報
Vector watercolor blot. Hand drawn blot on white background for your design. Save the Date, postcard, banner, logo.
- ID:77984589
- 作品種別:イラスト
- 作者名:Aksana Famina
EPS形式
のライセンスは、EPS形式のベクターファイルで提供されます。
このファイルを展開・編集するには、Adobe Illustrator 、CorelDRAW などの、ベクター編集ソフトが必要です。
他のライセンスではJPEG形式で提供されます。
作者によってテキスト(文字)が挿入されている作品は文字を含めそのまま提供されますので文字を差し替えてご使用される場合は、画像編集ソフト等で該当部分を加工・編集する必要があります。
キーワード
- abstract
- art
- artistic
- backdrop
- banner
- blot
- brush
- card
- collection
- color
- creative
- creativity
- decoration
- design
- drawing
- elegant
- element
- expressive
- freehand
- graphic
- hand
- hand drawn
- illustration
- ink
- invitation
- isolated
- modern
- multicolor
- paint
- paper
- party
- pastel
- poster
- scribble
- shape
- simple
- sketch
- splash
- stain
- stroke
- style
- template
- texture
- unusual
- wallpaper
- watercolor
- watercolour
類似作品
Isolated waterc...
Art hand paint ...
Colors watercol...
Blue watercolor...
Vector set of s...
Ink drop. Round...
Set of pink pai...
Abstract isolat...
Vector banner w...
blood splatter ...
Watercolor Pain...
Colorful waterc...
Set of colorful...
Vector watercol...
blood splatter ...
Hand painted wa...
Splash rainbow ...
Vector watercol...
Vector watercol...
expressive wate...
Vector ink pain...
Splash of charc...
Abstract colorf...
Grayscale abstr...
Set of abstract...
splash paint sp...
Color splashing...
Vector illustra...
Black ink paint...
Grunge backgoun...
watercolor fram...
Colorful Vector...
Colors watercol...
Dark red of sta...
Set of hand dra...
Handprint in co...
Watercolor Brig...
Vector abstract...
Vector watercol...
Beautiful trace...
Vector abstract...
creative waterc...
brush Icons set...
Set of cards wi...
fist on grung...
Abstract waterc...
Vector watercol...
hand print with...
Purple watercol...